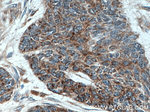
Involucrin Antibody in Immunohistochemistry (Paraffin) (IHC (P))

Search
Proteintech
Involucrin Polyclonal Antibody
{{$productOrderCtrl.translations['antibody.pdp.commerceCard.promotion.promotions']}}
{{$productOrderCtrl.translations['antibody.pdp.commerceCard.promotion.viewpromo']}}
{{$productOrderCtrl.translations['antibody.pdp.commerceCard.promotion.promocode']}}: {{promo.promoCode}} {{promo.promoTitle}} {{promo.promoDescription}}. {{$productOrderCtrl.translations['antibody.pdp.commerceCard.promotion.learnmore']}}
产品信息
55328-1-AP
已发表种属
宿主/亚型
分类
类型
抗原
偶联物
形式
浓度
规格
保存条件
运输条件
靶标信息
Involucrin, a component of the keratinocyte crosslinked envelope, is found in the cytoplasm and crosslinked to membrane proteins by transglutaminase. Involucrin is expressed in a range of stratified squamous epithelia, including the cornea. In normal epidermis, it is first expressed in the upper spinous layers, and in keratinocyte cultures it is expressed by all cells that have left the basal layer. Involucrin expression is abnormal in squamous cell carcinomas and premalignant lesions and is reduced in severe dysplasias of the larynx and cervix. Its gene is mapped to 1q21, among calpactin I light chain, trichohyalin, profillaggrin, loricrin, and calcyclin.
仅用于科研。不用于诊断过程。未经明确授权不得转售。